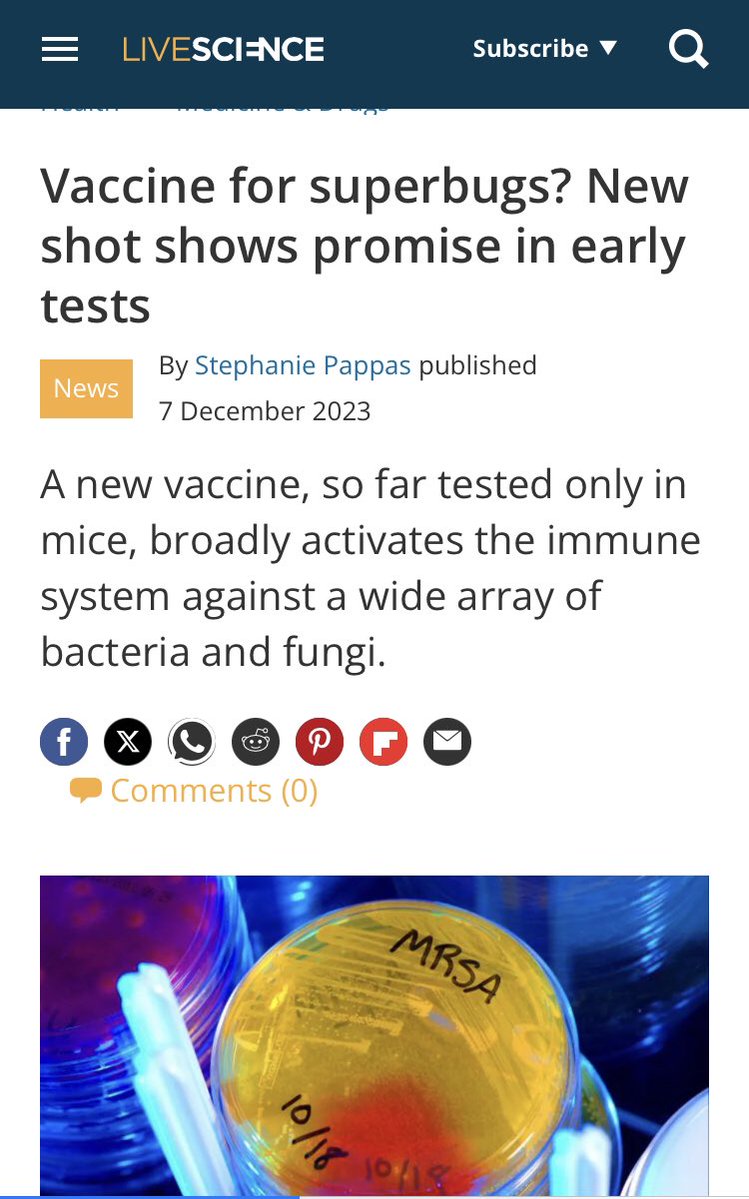

reSee.it - Related Post Feed

@ThingsHiddenn - Moriarty
This is worth your time if you want to watch something right now. Because this is what Twitter is attempting to do, and so are other companies like Google. Becoming an "everything app".

@DD_Geopolitics - DD Geopolitics
BUT WAIT! THERES MOOOOOORE! Part 2... https://t.co/4277M8GC5d

@Emilio2763 - 𝕰𝖒𝕲
It’s Just The Algorithm… Had ENOUGH Yet?…

@heckyessica - Jessica O’Donnell 🏈
I can promise that you do not know where this is going https://t.co/xqdHn0w4LT

@kacdnp91 - Kelly DNP🐭Functional/Integrative Med
Omg… wonder how much they get paid for this BS https://t.co/Qi09FpvL0W



@robertdunlap947 - Bobby D🎙
Oh my God😳. Apparently this is the content I’m going to produce today😂. You’re welcome👊 https://t.co/TvbIZ00pe7

@ecomarxi - Tiberius
This is the worst content I have ever seen. I am seriously considering ripping my eyes out so I don’t see the next one. https://t.co/LXiC5tUqt5


@Byoussef - Bassem Youssef
They won’t stop there https://t.co/no3LIercVX


@stillgray - Ian Miles Cheong
They. Want. You. Dead. https://t.co/QaHNsFbiv7

@InternetH0F - internet hall of fame
This is the best marketing ever LMAO https://t.co/ia5T8v0jS0




@DecentBackup - BackupDecentFiJC
What’s with the coordinated marketing campaigns for so many of these surface-level investigatooor/exposooor accounts lately? Wait a sec, lemme check something... *checks something* Ah, yes. Controlled bullshit. Sounds about right. https://t.co/xwcZ46pTo2

@myhiddenvalue - Not A Number
There must be some reason they're hiding this from us.... https://t.co/gTnDPwTnHE

@toobaffled - “Sudden And Unexpected”
They don’t want you to See this .. https://t.co/pzbWKPiVbj

@TheOfficial1984 - 1984
Do you still watch Netflix? TURN IT OFF. https://t.co/OfQdU4qOfr

@JakeG_Official - JAKEGTV
POV: You try watching the tech news after noticing enough to become antiseptic https://t.co/T9xB059j3q